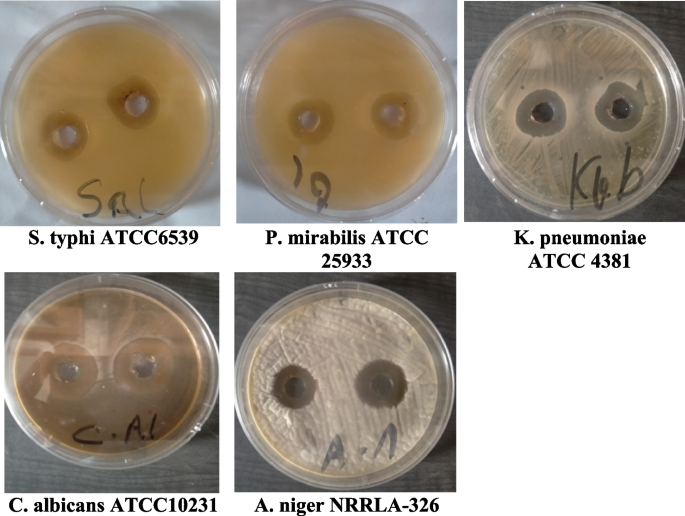
figure 5

- Research
- Open access
- Published:
Characterization, antimicrobial and antitumor activity of superoxide dismutase extracted from Egyptian honeybee venom (Apis mellifera lamarckii)
Journal of Genetic Engineering and Biotechnology volume 21, Article number: 21 (2023)
Abstract
Background
Superoxide dismutase is an important antioxidative stress enzyme which is found in honeybee venom and has a wide pharmaceutical and medical applications.
Results
We reported the purification and characterization of venom SOD from Egyptian honeybee Apis mellifera lamarckii and termed BVSOD. It was purified to homogeneity from the Egyptian honeybee venom. The purification procedures included crude extraction, DEAE-cellulose anion exchange column chromatography, and Sephacryl S-300 gel filtration column chromatography. The purified BVSOD is found to be homogeneous as investigated by native PAGE. It exhibited homodimeric structure with a molecular weight of native form of 32 kDa and subunits of 16.0 kDa. It displayed the maximum activity at pH 7.4. CuCl2, ZnCl2, and MgCl2 and elevated the activity of BVSOD, while CoCl2, FeCl2, and NiCl2 inhibited BVSOD activity. Potassium cyanide and hydrogen peroxide were most potent inhibitors for BVSOD activity suggesting that it is a Cu/Zn-SOD type.
Conclusions
The purified BVSOD is found to have antimicrobial and antitumor activities which can be used for various medical and clinical applications.
Background
Superoxide dismutases (SODs) are a family of antioxidant metalloenzymes which defend against oxidative stress resulting from reactive oxygen species by scavenging superoxide radicals [1, 2]. SODs are catalyzing the disproportionation of superoxide free radicals to H2O2 and H2O to protect cells against their harmful effects [3, 4]. SODs are classified into four groups according to active site metal species, Mn-SOD, Cu/Zn-SOD, Ni-SOD, and Fe-SOD [5,6,7,8,9]. SODs have increasing commercial applications in cosmetics, clinical nutrition, and pharmaceutical industries [10]. SODs are used as antioxidant drugs in many diseases [11]. SODs are found to have antiviral and anti-inflammatory activities [12]. SODs have been studied in many of insect species, and it plays a protective role against oxidative stress caused by environmental stressors such as cold, heat, heavy metals, starvation, insecticides, and pathogens [13,14,15,16]. Bee venom is a pharmacologically complex mixture containing active enzymes, peptides, and proteins [17]. Bee venom is a secretion of bee’s sting apparatus and used to protect bees from any enemies [18, 19]. Bee venom is found to have antibacterial, anti-inflammatory, radioprotective, antimutagenic, immunity-promoting, antinociceptive, anticancer, and hepatocyte-protective activities so it is used in treating many diseases in folk medicine [20,21,22,23,24]. The aim of the present work is to purify SOD from the Egyptian honeybee venom Apis mellifera lamarckii, comprehensively discuss their characteristics, with emphasis on their potential antibacterial and antitumor activities.
Materials and methods
Materials
Collection of venom
The honeybee colonies were obtained from governorate of Asuit Egyptian subspecies Apis mellifera lamarckii. Venom was extracted from workers. Five-hundred workers of foraging bees were catched at the colony entry and rapid freezed at − 20 °C to immobilized. Bees were handly dissected; venom reservoir and sting device were removed, then disrupted in Eppendorf with 2.5 ml of H2O, and then centrifuged at 12,000 × g, 5 min, 4 °C. The supernatants were obtained and designated venom extract.
Chemicals
Xanthine sodium salt, xanthine oxidase enzyme, cytochrome C from horse heart, nitroblue tetrazolium (NBT), dimethyl sulfoxide (DMSO), phenyl methosulfate (PMS), phenymethylsulfonyl fluoride (PMSF), 1,4 dithiothreitol (DTT), 1,10 phenanthroline, trypan blue dye, bovine serum albumin (BSA), blue dextran, crystal violet, Sephacryl S-300, DEAE cellulose, and kits of gel filtration molecular weight marker were product of Sigma Co. SDS molecular weight marker proteins were purchased from Pharmacia Co., DMEM, fetal bovine serum, HEPES buffer solution, RPMI-1640, gentamycin, and L-glutamine are purchased from Lonza, Belgium.
Methods
SOD activity assay
SOD activity assay was based on the SOD ability to inhibit reduction of cytochrome C by scavenging superoxide anion formed by xanthine-xanthine oxidase system. The reaction mixture assay is 1.0 ml buffer 20 mmol L−1 potassium phosphate (pH 7.8), containing 0.1 mM EDTA, 0.01 mM cytochrome C, and 0.05 mM sodium xanthine. Reaction started by 21 munit of xanthine oxidase that reacts with sodium xanthine (substrate) producing superoxide anion that makes a reduction to cytochrome C at 550 nm. One unit activity of SOD is the amount which causes 50% reaction inhibition for reduction rate of cytochrome C [25].
Staining of SOD activity on polyacrylamide gels
Staining of SOD activity was determined according to Weisiger and Fridovich method [26]. Determination of activity of SOD following electrophoresis was carried out by a reaction mixture containing phenazine methosulfate (PMS) and nitroblue tetrazolium salt (NBT) that produced superoxide anions, and then, formazan was formed by reduction of NBT by superoxide. Achromatic zones appeared on gel where superoxide radicals disappeared due to SOD activity preventing the NBT reduction. A buffered reaction mixture of NBT and PMS applied on gels and then exposed for minutes to sun daylight until achromatic zones indicating SOD activity formed on a blue background of gel.
Purification of bee venom superoxide dismutase
The BVSOD was isolated from Apis mellifera lamarckii by two chromatographic steps: chromatography on DEAE-cellulose column and Sephacryl S-300 column. Venom extract was loaded onto DEAE-cellulose column (12 cm × 2.4 cm i.d.) pre-equilibrated with 20 mmol L−1 potassium phosphate buffer (pH 7.4). The elution of adsorbed proteins was carried out with stepwise NaCl gradient of 0 to 1 M in the same buffer at flow rate of 60 ml/h. Fractions of 3 ml were collected and analyzed for protein content and enzyme activity. Fractions containing SOD activity were pooled and concentrated. The concentrated enzyme was processed on a column Sephacryl S-300 (142 cm × 1.75 cm i.d.) which equilibrated and run with 20 mmol L−1 potassium phosphate buffer (pH 7.4) in a 30 ml/h flow rate. Fractions of 2 ml volume containing SOD were pooled. The protein concentration was measured following the method of Bradford, by using bovine serum albumin as standard [27].
Native and SDS/PAGE gel electrophoresis
Purification steps, venom extract, chromatography on DEAE-cellulose column, and chromatography on Sephacryl S-300 column fraction are investigated by 7% native PAGE electrophoresis. Gel electrophoresis was achieved using 7% native PAGE using method of Smith [28] and SDS/PAGE which was carried out with 12% PAGE using method of Laemmli [29]. The molecular weight of purified SOD enzyme was determined using SDS-PAGE according to Weber and Osborn [30]. Proteins stained using Coomassie brilliant blue (R-250) 0.25% conc. SOD activity stained on PAGE according to Weisiger and Fridovich [26].
Antimicrobial activity determination
A total of 500 µg/ml of purified BVSOD was dissolved by methanol, and 50-μl aliquots were soaked on discs of filter paper (Whatman No. 1) and dried [31]. The discs were distributed on agar plates surface inoculated with microbes to be tested and incubated for 24 h at 37 °C for bacteria and 48 h at 30 °C for fungi and yeast. Yeast and bacteria were grown on nutrient agar; fungi were grown on PDA (DSMZ 130) medium. After incubation, the inhibition zones of diameter were measured for tested microorganisms: Proteus mirabilis ATCC 25,933, Salmonella typhi ATCC6539, Klebsiella pneumoniae ATCC 43,816, Candida albicans ATCC10231, and Aspergillus niger NRRLA-326. Oxytetracycline (OT) was used as reference standard. The tested microbes were obtained from National Research Center, Egypt, Microbial Chemistry Department, Culture Collection Center.
Antitumor activity determination
Human hepatocellular carcinoma cell line (HepG-2 cells) and human breast cancer cell line (MCF-7 cells) were obtained from VACSERA, Egypt, Tissue Culture Unit. The cells were propagated in medium of Dulbecco’s modified Eagle with HEPES buffer, 50 µg/ml gentamycin, 10% heat-inactivated fetal bovine serum, and 1% L-glutamine. Cells were incubated in 5% CO2 at 37 °C and subcultured two times a week. For assay of cytotoxicity, 100 µl medium was seeded in 96-well plate with 1 × 104 cells/well concentration. Fresh growth medium containing purified BVSOD with different concentrations was added. After incubation for 24 h at 37 °C, the yield of viable cells was spectrophotometrically determined at 490 nm. Treated cells and control cells (in the absence of purified BVSOD) were compared. The cytotoxic effect of purified BVSOD was calculated by [(ODt/ODc)] × 100% where ODt is optical density mean of treated wells with purified BVSOD, and ODc is optical density mean of untreated cells. The survival curve (relation between purified BVSOD concentration and surviving cells) was plotted. A total of 50% concentration of inhibition (IC50) was determined from graphic plots of curve for each concentration. The microscopic examination of the tumor cells treated with purified BVSOD and control cells was carried out. The cells were stained, and cellular morphology was investigated using an inverted microscope and a digital microscopy camera to capture the images [32,33,34].
Results
Purification of superoxide dismutase
The superoxide dismutase starting specific activity in venom extract was 321 units/mg protein. One peak of superoxide dismutase activity (BVSOD) was resolved from DEAE cellulose and was eluted with 0 M NaCl of 20 mmol L−1 potassium phosphate buffer (pH 7.4) (Fig. 1). BVSOD-specific activity of DEAE-cellulose pooled fraction was increased 1.83-fold over venom crude extract with 53.9% recovery. The elution profile of Sephacryl S-300 column showed one peak of superoxide dismutase activity (Fig. 2). After chromatography, the specific activity of superoxide dismutase enzyme was raised to 1250 units/mg protein that represent 3.89-fold with 21.0% yield (Table 1). The molecular weight of BVSOD was determined from gel filtration column elution volume to be 32 kDa.
Electrophoretic analysis
Purification steps, venom extract, DEAE cellulose, and Sephacryl S-300 fraction were loaded on 7% native PAGE electrophoresis. One band of protein agreed with SOD activity band denoting purity of BVSOD preparation (Fig. 3 a and b). Electrophoretic analysis of BVSOD on SDS/PAGE was compared to markers protein and showed its molecular weight subunit to be 16 kDa (Fig. 3c).
a Electrophoretic analysis of superoxide dismutase (enzyme protein pattern) of the different purification steps on 7% native polyacrylamide gel: (1) crude venom, (2) DEAE-cellulose fraction, and (3) Sephacryl S-300 purified fraction of BVSOD. b Electrophoretic analysis of superoxide dismutase (enzyme activity pattern) of the different purification steps on 7% native polyacrylamide gel: (1) crude venom, (2) DEAE-cellulose fraction, and (3) Sephacryl S-300 purified fraction of BVSOD. c Subunit molecular weight determination by electrophoretic analysis of purified BVSOD on 12% SDS–polyacrylamide gel: (1) molecular weight marker proteins and (2) purified superoxide dismutase
Effect of pH
The pH effect on purified BVSOD was carried out utilizing buffer 20 mmol L−1 potassium phosphate with values of pH between (5.7 and 8.0). The highest activity of BVSOD was recorded at pH 7.4 (Fig. 4).
Effect of cations and inhibitors
The divalent cations effect and inhibitors effect on activity of purified BVSOD was measured after preincubation at 37 °C with 2 and 5 mM of each cation and each inhibitor. A control without cations and inhibitors was taken 100% activity. CuCl2, ZnCl2, and MgCl2 elevated activity of BVSOD, while FeCl2, CoCl2, and NiCl2 inhibited activity of BVSOD (Table 2). Potassium cyanide and hydrogen peroxide were most potent inhibitors for BVSOD activity. DL-Dithiothreitol, EDTA, 1,10-phenanthroline, β-mercaptoethanol, iodoacetamide, phenylmethylsulfonyl fluoride (PMSF), and potassium dichromate inhibited BVSOD activity (Table 3).
Antimicrobial and antitumor activity
The purified BVSOD was screened for its antimicrobial activity. All data expressed as the mean of three reads, while no difference between reads has been observed. The inhibition zone for purified BVSOD was determined and compared with the reference standard (Fig. 5). Results of antimicrobial screening are shown in Table 4. The data obtained showed that BVSOD have an antimicrobial activity. Results showed that the BVSOD exhibited good antibacterial activity against Proteus mirabilis ATCC 25,933, Salmonella typhi ATCC6539, and Klebsiella pneumoniae ATCC 43,816 with inhibition zone (13 mm, 15 mm, and 15 mm), respectively. On the other hand, the antifungal activity of BVSOD was also measured, and the obtained results showed that BVSOD displayed a potent anticandidal activity with inhibition zone 22 mm, while the activity was also strong against Aspergillus niger with inhibition zone 18 mm. The purified BVSOD was screened for its antitumor activity (Tables 5) using human hepatocellular carcinoma cell line (HepG-2 cells) and human breast cancer cell line (MCF-7 cells). BVSOD was found to have antitumor activity (Figs. 6 and 7).
Morphological evaluation of cytotoxicity of purified BVSOD against HepG2 cell line using different concentrations and compared with HepG2 non-treated cell as a control. a HepG2 cells treated with BVSOD at 500 µg/ml. b HepG2 cells treated with BVSOD at 62.5 µg/ml. c HepG2 cells treated with BVSOD at 7.8 µg/ml. d HepG2cells non-treated (cell control)
Discussion
It is well established that SOD (EC 1.15.1.1) serves a key antioxidant role [35]. SODs have been studied in venoms of many parasitoids such as Cotesia chilonis, Leptopilina boulardi, Diversinervus elegans, and Tetrastichus brontispae [36,37,38]; these studies suggest that SOD is present in parasitoids venom. The present study demonstrated a simple and reproducible purification method of the superoxide dismutase from venom of Egyptian honeybee Apis mellifera lamarckii. The BVSOD was isolated from Apis mellifera lamarckii by two chromatographic steps. The chromatographic profile obtained from DEAE-cellulose column showed a well-defined fraction identified as BVSOD. The pooled fraction-specific activity of BVSOD was increased 1.83-fold over venom extract with 53.9% recovery. After chromatography on Sephacryl S-300 column, BVSOD-specific activity was raised to 1250 units/mg protein that represent purification fold of 3.89 and 21.0% yield. Present findings are comparative to SOD of Italian honeybee Apis mellifera royal jelly previously isolated with 53.05 units/mg specific activity [39]. Purification steps are investigated by 7% native PAGE electrophoresis. One protein band agreed with BVSOD activity band denoting purity of BVSOD preparation. The molecular weight of BVSOD was investigated from gel filtration column elution volume to be 32 kDa. Electrophoretic analysis of BVSOD and protein markers on SDS/PAGE was compared and showed BVSOD molecular weight subunit to be 16 kDa; this is consistent with SOD previously isolated from silkworm, Bombyx mori [40], with SOD isolated from Drosophila melanogaster [41] and 29.3 kDa from midgut of Helicoverpa armigera larvae [42]. The effect of pH on the purified BVSOD was carried out utilizing buffer 20 mmol L−1 potassium phosphate with values of pH between 5.7 and 8.0. The highest activity of BVSOD was recorded at pH 7.4, while midgut of Helicoverpa armigera larvae SOD showed maximum activity at pH 11.0 [42]. CuCl2, ZnCl2, and MgCl2 elevated the activity of BVSOD, while FeCl2, CoCl2, and NiCl2 inhibited activity of BVSOD. These results are in accordance with SOD from muscle tissue of the shrimp Macrobrachium nipponense and from Marinomonas sp. bacteria which were markedly enhanced by ZnCl2 and inhibited by FeCl2 [43, 44]. Differentiation between SODs classes is based on selective chemicals inhibition [45, 46]. Types of SODs can be differentiated by its inhibition susceptibility to hydrogen peroxide (H2O2) and potassium cyanide (KCN) [47,48,49]. It is well-known that the superoxide dismutase isoenzyme that is very sensitive to potassium cyanide inhibition and inhibited with hydrogen peroxide is cupper/zinc containing isoenzyme [10, 50]. In this study, potassium cyanide (KCN) and hydrogen peroxide (H2O2) are found to be potent inhibitors of purified BVSOD activity suggesting that it is a copper/zinc containing enzyme. 1,10-Phenanthroline and EDTA-inhibited BVSOD activity indicate that BVSOD is a metalloenzyme. Dithiothreitol and β-mercaptoethanol-inhibited BVSOD activity indicate that active site containing − SH groups play a major role for enzyme activity. Similarly, SOD of Radix lithospermi seed is sensitive to thiol compounds [46]. PMSF and iodoacetamide inhibited BVSOD activity indicating that serine, cysteine, methionine, and histidine residues have important effects on enzyme structure and activity; these results are in accordance with SOD of chicken liver [47]. The activity inhibition of BVSOD with K2Cr2O7 may be due to metal prosthetic groups oxidation which is a principle for enzyme activity. SOD of muscle tissue of the shrimp is also susceptible to K2Cr2O7 [43]. Antimicrobial activity results showed that BVSOD have a good antibacterial activity against Proteus mirabilis ATCC 25,933, Salmonella typhi ATCC6539, and Klebsiella pneumoniae ATCC 43,816. BVSOD displayed a potent anticandidal activity, while the activity was also strong against Aspergillus niger. BVSOD was screened for its antitumor activity using human hepatocellular carcinoma cell line (HepG-2 cells) and human breast cancer cell line (MCF-7 cells). BVSOD was found to have a potent antitumor activity against HepG-2 cells and have an inhibitory effect against MCF-7 cells. A total of 500 µg of BVSOD causes 98.03 inhibition for HepG-2 cells, and 1 µg of BVSOD causes 10.58 inhibition. The 50% inhibitory concentration (IC50) of BVSOD against HepG2 cell was estimated to be 6.67 µg. Morphological evaluation of cytotoxicity of BVSOD against HepG2 cell line was carried out using different concentrations of BVSOD and compared with HepG2 non-treated cell as a control.
Conclusions
This study presents a simple, fast, and reproducible isolation and characterized protocols of SOD from venom of Egyptian honeybee Apis mellifera lamarckii. The method can scaled up from the laboratory level to semi-pilot and pilot levels for production of this enzyme in larger scales. The purified BVSOD found to have antimicrobial and antitumor activities which can be used for various medical and clinical applications. The present study will help in finding the optimum conditions for the enzyme activity, and this will be helpful in BVSOD uses in various applications with high efficiency.
Availability of data and materials
All data generated or analyzed during this study are included in this published article.
Abbreviations
- BVSOD:
-
Bee venom superoxide dismutase
- NBT:
-
Nitroblue tetrazolium
- DMSO:
-
Dimethyl sulfoxide
- PMS:
-
Phenyl methosulfate
- PMSF:
-
Phenylmethylsulfonyl fluoride
- DTT:
-
1,4-Dithiothreitol
- BSA:
-
Bovine serum albumin
- DEAE-cellulose:
-
Diethylaminoethyl cellulose
- DMEM:
-
Dulbecco’s Modified Eagle Medium
- HEPES:
-
(4-(2-Hydroxyethyl)-1-piperazineethanesulfonic acid)
- HepG-2 cells:
-
Human hepatocellular carcinoma cell line
- MCF-7 cells:
-
Human breast cancer cell line
References
De ObesoFernández Del Valle A, Scheckhuber CQ (2022) Superoxide dismutases in eukaryotic microorganisms: four case studies. Antioxidants (Basel) 11(2):188. https://doi.org/10.3390/antiox11020188.1
Fujii J, Homma T, Osaki TH (2022) Superoxide radicals in the execution of cell death. Antioxidants (Basel) 11(3):501. https://doi.org/10.3390/antiox11030501
Oka S, Hirai J, Yasukawa T, Nakahara Y, Inoue YH (2015) A correlation of reactive oxygen species accumulation by depletion of superoxide dismutases with age-dependent impairment in the nervous system and muscles of Drosophila adults. Biogerontology 16(4):485–501. https://doi.org/10.1007/s10522-015-9570-3
Tabunoki H, Gorman MJ, Dittmer NT, Kanost MR (2016) Superoxide dismutase 2 knockdown leads to defects in locomotor activity, sensitivity to paraquat, and increased cuticle pigmentation in Triboliumcastaneum. Sci Rep 8(6):29583. https://doi.org/10.1038/srep29583
Bao Y, Li L, Xu F, Zhang G (2009) Intracellular copper/zinc superoxide dismutase from bay scallop Argopecten irradians: its gene structure, mRNA expression and recombinant protein. Fish Shellfish Immunol 27(2):210–220. https://doi.org/10.1016/j.fsi.2009.04.005
Bittencourt SET, Castro LA, Farias SE, Bao SN, Schrank A, Vainstein MH (2004) Purification and ultrastructral localization of copper/zinc superoxide dismutase from entomopathogenic and a caricide fungus Metarhizium anisopiia. Res Microbiol 155(8):681–687. https://doi.org/10.1016/j.resmic
Sheng L, Zheng X, Tong H, Liu S, Du J, Liu Q (2004) Purification and characterization of cytosolic isoenzyme III of Cu, Zn-superoxide dismutase from tobacco leaves. Plant Sci 167(6):1235–1241. https://doi.org/10.1016/j.plantsci.2004.06.022
Miao L, Daret K, Clair S (2009) Regulation of superoxide dismutase genes: implications in disease. Free Radic Biol Med 47(4):344–356. https://doi.org/10.1016/j.freeradbiomed
Ghosh K, Tyagi N, Kumar P, Singh U, el Go N (2010) Stabilization of Mn (II) and Mn (III) in mononuclear complexes derived from tridentate ligands with N2O donors: synthesis, crystal structure, superoxide dismutase activity and DNA interaction studies. J Inorg Biochem 104(1):9–18. https://doi.org/10.1016/j.jinorgbio.2009.09.014
Desai K, Sivakami S (2007) Purification and biochemical characterization of a superoxide dismutase from the soluble fraction of the cyanobacterium Spirulina platensis. World J Microbiol Biotechnol 23(12):1661–1666. https://doi.org/10.1007/s11274-007-9413-8
Muzykantov VR (2001) Targeting of superoxide dismutase and catalase to vascular endothelium. J Control Release 71(1):1–21. https://doi.org/10.1016/s0168-3659(01)00215-2
D’Agnillo F, Chang T (1998) Polyhemoglobin-superoxide dismutase-catalase as a blood substitute with antioxidant properties. Nat B iotechnol 16(7):667–671. https://doi.org/10.1038/nbt0798-667
Jia H, Sun R, Shi W, Yan Y, Li H, Guo X, Xu B (2014) Characterization of a mitochondrial manganese superoxide dismutase gene from Apis cerana cerana and its role in oxidative stress. J Insect Physiol 60:68–79. https://doi.org/10.1016/j.jinsphys
Koo HN, Lee SG, Yun SH, Kim HK, Choi YS, Kim GH (2016) Comparative analyses of Cu-Zn superoxide dismutase (SOD1) and thioredoxin reductase (TrxR) at the mRNA level between Apis mellifera Land Apis cerana F(Hymenoptera: Apidae) under stress conditions. J Insect Sci 16(1):4. https://doi.org/10.1093/jisesa/iev159
Nikolić TV, Purać J, Orčić S, Kojić D, Vujanović D, Stanimirović Z, Blagojević DP (2015) Environmental effects on superoxide dismutase and catalase activity and expression in honeybee. Arch Insect Biochem Physiol 90(4):181–194. https://doi.org/10.1002/arch.21253
Wu H, Zhang Y, Shi X, Zhang J, Ma E (2017) Overexpression of Mn-superoxide dismutase in Oxya chinensismediates increased malathion tolerance. Chemosphere 181:352–359. https://doi.org/10.1016/j.chemosphere
Vaerenbergh VM, Debyser G, Devreese B, de Graaf DC (2014) Exploring the hidden honeybee (Apismellifera) venom proteome by integrating a combinatorial peptide ligand library approach with FTMS. J Proteomics 17(99):169–178. https://doi.org/10.1016/j.jprot.2013.04.039
Wehbe R, Frangieh J, Rima M, El Obeid D, Sabatier JM, Fajloun Z (2019) Bee venom: overview of main compounds and bioactivities for therapeutic interests. Molecules 24(16):2997. https://doi.org/10.3390/molecules24162997
Hossen MS, Shapla UM, Gan SH, Khalil MI (2016) Impact of bee venom enzymes on diseases and immune responses. Molecules 22(1):25. https://doi.org/10.3390/molecules22010025
Lim B-S, Moon HJ, Li DX, Gil M, Min JK, Lee G, Bae H, Kim SK, Min B-I (2013) Effect of bee venom acupuncture on oxaliplatin-induced cold allodynia in rats. Evid Based Complement Alternat Med 2013:369324. https://doi.org/10.1155/2013/369324
Park YC, Koh PS, Seo BK, Lee JW, Cho NS, Park HS, Park DS, Baek YH (2014) Long-term effectiveness of bee venom acupuncture and physiotherapy in the treatment of adhesive capsulitis: a one-year follow-up analysis of a previous randomized controlled trial. J Altern Complement Med 20(12):919–924. https://doi.org/10.1089/acm.2014.0220
Zidan HAG, Mostafa ZK, Ibrahim MA, Haggag SI, Darwish DA, Elfiky AA (2018) Venom composition of Egyptian and Carniolan honeybee, Apismellifera L. affected by collection methods. Egypt Acad J Biol Sci 11(4):59–71. https://doi.org/10.21608/EAJBSA.2018.17733
Abdel-Monsef MM, Zidan HA, Darwish DA, Masoud HM, Helmy MS, Ibrahim MA (2020) Biochemical isolation and characterization of hyaluronidase enzyme from venom of Egyptian honeybee Apismelliferalamarckii. J Apic Sci 64:153–164. https://doi.org/10.2478/jas-2020-0015
Darwish DA, Masoud HMM, Abdel-Monsef MM, Helmy MS, Zidan HA, Ibrahim MA (2021) Phospholipase A2 enzyme from the venom of Egyptian honeybee Apis mellifera lamarckii with anti-platelet aggregation and anti-coagulation activities. J Genet Eng Biotechnol. 19(1):10. https://doi.org/10.1186/s43141-020-00112-z
McCord JM, Fridovich I (1969) Superoxide dismutase: an enzymic function for erythrocuprein (hemocuprein). J Biol Chem 244:6049–6055
Weisiger RA, Fridovich I (1973) Superoxide dismutase: organelle specificity. J Biol Chem 248:3582–3592
Bradford MM (1976) A rapid and sensitive method for the quantitation of microgram quantities of protein utilizing the principle of protein -dye binding. Anal Biochem 72:248–254
Smith I (1969) Acrylamide gel disc electrophoresis. In: Smith I (ed) Electrophoretic techniques. Academic press, New York, pp 365–515
Laemmli UK (1970) Cleavage of structural proteins during the assembly of the head of Bacteriophage T4. Nature 227:680–685
Weber K, Osborn M (1969) The reliability of molecular weight determinations by dodecyl sulfate polyacrylamide gel electrophoresis. J Biol Chem 244:4406–4412
Abd-El-Maksoud MA, Khatab TK, Maigali SS, Soliman FM, Hamed AA (2018) Chemistry of phosphorus ylides: part 46—efficient synthesis andbiological evaluation of new phosphorus, sulfur, and selenium pyrazole derivatives. J Heterocycl Chem 55(12):2883–2892. https://doi.org/10.1002/jhet.3361
Mosmann T (1983) Rapid colorimetric assay for cellular growth and survival: application to proliferation and cytotoxicity assays. J Immunol Methods 65(1–2):55–63. https://doi.org/10.1016/0022-1759(83)90303-4
Gomha SM, Riyadh SM, Mahmmoud EA, Elaasser MM (2015) Synthesis and anticancer activities of thiazoles, 1,3-thiazines, and thiazolidine using chitosan-grafted-poly (vinylpyridine) as basic catalyst. Heterocycles 91(6):1227–1243. https://doi.org/10.1002/CHIN.201538150
Abo-Ashour MF, Eldehna WM, Nocentini A, Bonardi A, Bua S, Ibrahim HS, Elaasser MM, Kryštof V, Jorda R, Gratteri P, Abou-Seri SM, Supuran CT (2019) 3-Hydrazinoisatin-based benzenesulfonamides as novel carbonic anhydrase inhibitors endowed with anticancer activity: synthesis, in vitro biological evaluation and in silico insights. Eur J Med Chem 184:111768. https://doi.org/10.1016/j.ejmech.2019.111768
Ighodaro OM, Akinloye OA (2018) First line defence antioxidants-superoxide dismutase (SOD), catalase (CAT) and glutathione peroxidase (GPX): their fundamental role in the entire antioxidant defence grid 54(4):287–293. https://doi.org/10.1016/j.ajme.2017.09.001.
Liu NY, Wang JQ, Zhang ZB, Huang JM, Zhu JY (2017) Unraveling the venom components of an encyrtid endoparasitoid wasp Diversinervus elegans. Toxicon 15(136):15–26. https://doi.org/10.1016/j.toxicon.2017.06.011
Teng ZW, Xiong SJ, Xu G, Gan SY, Chen X, Stanley D, Fang Q (2017) Protein discovery: combined transcriptomic and proteomic analyses of venom from the endoparasitoid Cotesia chilonis (Hymenoptera: Braconidae). Toxins 9(4):135. https://doi.org/10.3390/toxins9040135
Liu NY, Xu ZW, Yan W, Ren XM, Zhang ZQ, Zhu JY (2018) Venomics reveals novel ion transport peptide-likes (ITPLs) from the parasitoid wasp Tetrastichus brontispae. Toxicon. https://doi.org/10.1016/j.toxicon.2017.11.008
Li-E M, Jia L, Ke-Wu L, Yan J, Xiao-Wen L, Xin L (2004) Isolation, purification and characterization of superoxide dismutase from royal jelly of the Italian worker bee. Apis mellifera. Acta Entomologica Sinica 47(2):171–177 (http://www.insect.org.cn/EN/Y2004/V47/I2/171)
Yamamoto K, Zhang P, Miake F, Kashige N, Aso Y, Banno Y, Fujii H (2005) Cloning, expression and characterization of theta-class glutathione S-transferase from the silkworm, Bombyx mori. Comp Biochem Physiol B Biochem Mol Biol 141(3):340–346. https://doi.org/10.1016/j.cbpc.2005.04.012
Lee YM, Misra HP, Ayala FJ (1981) Superoxide dismutase in Drosophila melanogaster: biochemical and structural characterization of allozyme variants. Proc Natl Acad Sci U S A 78(11):7052–7055. https://doi.org/10.1073/pnas.78.11.7052
Lomate PR, Sangole KP, Sunkar R, Hivrale VK (2015) Superoxide dismutase activities in the midgut of Helicoverpa armigera larvae: identification and biochemical properties of a manganese superoxide dismutase. Insect Physiology 5:13–20. https://doi.org/10.2147/OAIP.S84053
Yao CL, Wang AL, Wang WN, Sun RY (2004) Purification and partial characterization of Mn superoxide dismutase from muscle tissue of the shrimp Macrobrochiumnipponense. Aquaculture 241:621–631. https://doi.org/10.1016/j.aquaculture.2004.08.023
Zheng Z, Jiang YH, Miao JL, Wang QF, Zhang BT, Li GY (2006) Purification and characterization of a cold-active iron superoxide dismutase from a psychrophilic bacterium, Marinomonas sp. NJ522. Biotechnol Lett 28:85–88. https://doi.org/10.1007/s10529-005-4951-3
Chen JR, Weng CN, Ho TY, Cheng IC, Lai SS (2000) Identification of the copper-zinc superoxide dismutase activity in Mycoplasma hyopneumoniae. Vet Microbiol 73:301–310. https://doi.org/10.1016/s0378-1135(99)00170-4
Haddad N, Yuan Q (2005) Purification and some properties of Cu/Zn superoxide dismutase from Radix lethospermi seed, kind of Chinese traditional medicine. J Chromatogr B Analyt Technol Biomed Life Sci 818(2):123–131. https://doi.org/10.1016/j.jchromb.2004.12.010
Öztürk-Ürek R, Tarhan L (2001) Purification and characterization of superoxide dismutase from chicken liver. Comp Biochem Physiol B Biochem Mol Biol 128(2):205–212. https://doi.org/10.1016/s1096-4959(00)00300-6
Babitha MP, Prakash; H. S. and Shetty, H. S. (2002) Purification and partial characterization of manganese superoxide dismutase from downy mildew resistant pearl millet seedlings inoculated with Sclerospora graminicola. Plant Sci 163:917–924. https://doi.org/10.1016/S0168-9452(02)00238-8
Ken CF, Lee CC, Duan KJ, Lin CT (2005) Unusual stability of manganese superoxide dismutase from a new species, Tatumella ptyseosct : its gene structure, expression and enzyme properties. Protein Expr Purif 40:42–50. https://doi.org/10.1016/j.pep.2004.10.003
He N, Li Q, Sun D, Ling X (2008) Isolation, purification and characterization of superoxide dismutase from garlic. Biochem Eng J 38:33–38. https://doi.org/10.1016/j.bej.2007.06.005
Acknowledgements
This study is supported by the National Research Centre, Egypt, Proteome Research Laboratory.
Funding
This research received no specific grant from any funding agency in the public, commercial, or not-for-profit sectors.
Author information
Authors and Affiliations
Contributions
MMA and DAD suggested the work point, designed the experiments, performed the experimental part of the work, interpreted the data, and shared in writing the manuscript. HAZ collect venom samples. AAH carried out the microbiological experiments. MAI follows up the study, provided advice throughout the work, and revised the manuscript. The authors read and approved the final manuscript.
Corresponding author
Ethics declarations
Ethics approval and consent to participate
Not applicable.
Consent for publication
Not applicable.
Competing interests
The authors declare that they have no competing interests.
Additional information
Publisher’s Note
Springer Nature remains neutral with regard to jurisdictional claims in published maps and institutional affiliations.
Rights and permissions
Open Access This article is licensed under a Creative Commons Attribution 4.0 International License, which permits use, sharing, adaptation, distribution and reproduction in any medium or format, as long as you give appropriate credit to the original author(s) and the source, provide a link to the Creative Commons licence, and indicate if changes were made. The images or other third party material in this article are included in the article's Creative Commons licence, unless indicated otherwise in a credit line to the material. If material is not included in the article's Creative Commons licence and your intended use is not permitted by statutory regulation or exceeds the permitted use, you will need to obtain permission directly from the copyright holder. To view a copy of this licence, visit http://creativecommons.org/licenses/by/4.0/.
About this article
Cite this article
Abdel-Monsef, M.M., Darwish, D.A., Zidan, H.A. et al. Characterization, antimicrobial and antitumor activity of superoxide dismutase extracted from Egyptian honeybee venom (Apis mellifera lamarckii). J Genet Eng Biotechnol 21, 21 (2023). https://doi.org/10.1186/s43141-023-00470-4
Received:
Accepted:
Published:
DOI: https://doi.org/10.1186/s43141-023-00470-4